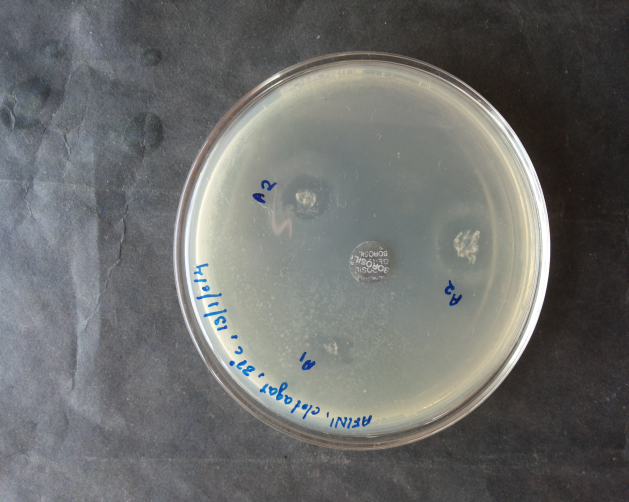
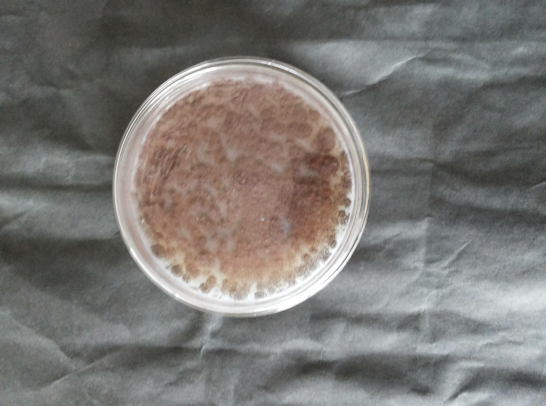
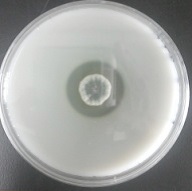

SIAS-Centre for Scientific Research (SIAS-CSR), SAFI Institute of Advanced Study, Rasiya Nagar, Vazhayoor East P. O., 673633, (Via.) Ramanattukara, Malappuram Dist., Kerala State, India
Email: soorajsn85@gmail.com
Received: 06 Sep 2016 Revised and Accepted: 05 0ct 2016
ABSTRACT
Objective: This work was undertaken with the aim of isolating and screening fungal soil isolates with fibrinolytic activity.
Methods: Soil sample near slaughter house was collected and screened for fibrinolytic activity by using fibrin-agar. Enzyme production was optimized under various parameters like pH, temperature, substrate concentration and purified partially by ammonium sulphate precipitation. The stability of the partially purified enzyme was analyzed under the influence of a wide range of pH, temperature, and substrate concentrations.
Results: Among the seven isolates screened, Aspergillus carbonarius S-CSR-0007 exhibited largest clear zone and was selected for further studies. Among the various substrates tested casein was found to support the highest caseinolytic activity of 816 U/ml and fibrinolytic activity of 510 U/ml. The culture supernatant of A. carbonarius S-CSR-0007 was fractionated by ammonium sulfate precipitation followed by dialysis, and maximum activity was obtained in the fraction with 80% ammonium sulfate, with an enzyme activity of 1200 U/ml using tyrosine as standard. The partially purified fibrinolytic enzyme showed optimal activity at 45 °C and pH 7.0. The enzyme was stable up to a temperature of 50 °C and pH 8.0, and the optimum substrate concentration was 4%.
Conclusion: The crude enzyme showed high blood clot lysis activity, which may be a good candidate in the pharmaceutical industry. However, more studies need to be carried out to establish its clinical use.
Keywords: Ammonium sulphate precipitation, Aspergillus carbonarius S-CSR-0007, Fibrin, Fibrinolytic enzyme
© 2016 The Authors. Published by Innovare Academic Sciences Pvt Ltd. This is an open access article under the CC BY license (http://creativecommons.org/licenses/by/4. 0/)
DOI: http://dx.doi.org/10.22159/ijpps.2016v8i12.15069
INTRODUCTION
The fibrinolytic enzyme is a well-known subclass of proteinases which has an ability to degrade protein [1]. Fibrin is the main component of a blood clot, and it is normally formed from fibrinogen by the action of thrombin (E. C.21.5). Intravascular thrombosis, the accumulation of fibrin in blood vessels or in a chamber of heart, easily causes myocardial infarction and other cardiovascular diseases (CVD), resulted in 17 million deaths every year as per the report of World Health Organization (WHO) [2]. Disorders of blood clotting and fibrinolysis are serious medical problems leading to cerebral and myocardial infarction [3]. Many blood clot-dissolving agents, such as urokinase, streptokinase, and tissue plasminogen activator (t-PA), have been utilized in clinical treatments for CVD which activate plasminogen into active plasmin to degrade fibrin and plasmin-like proteins which directly degrade fibrin thereby dislodging thrombin rapidly and completely. Although these agents are used widely today, their expensive prices and undesirable side effects, prompt researchers to search for cheaper and safer resources; the number of proteases that can interfere with blood clotting have been purified and characterized from various sources including microorganisms. Microbial fibrinolytic enzymes are classified into three types: serine protease, metalloprotease and mixture of both serine and metalloprotease [4]. Major protein component of a blood clot, fibrin is formed from fibrinogen via proteolysis by thrombin. Fibrin clots can be hydrolysed by plasmin to avoid thrombosis in a blood vessel.
Fibrinolysis is of two types; primary fibrinolysis, is a normal body process and secondary fibrinolysis, is the breakdown of clots due to medicine, a medical disorder or some other cause. In fibrinolysis, the product of coagulation is broken down [5]. Plasmin cuts the fibrin mesh leading to the production of fragments and are cleaved by other proteases or by the kidney and liver. Plasminogen has an affinity to clot so it is incorporated to it when formed, but cannot cleave fibrin. Tissue plasminogen activator is released into the body very slowly by the damaged endothelium of blood vessels, such as after bleeding stopped, the clot broken down by the plasminogen which is trapped within the clot. Tissue plasminogen activator also inhibited by plasminogen activator inhibitor 1 and plasminogen activator inhibitor 2, further, plasmin generation by producing active forms of t-PA and urokinase. When plasmin breaks down fibrin, fibrin degradation products (soluble parts) are produced, compete with thrombin, slow down clot formation by preventing fibrinogen to fibrin conversion. This can be seen in TCT (clotting time test), which is prolonged in person that has active fibrinolysis.
Although fibrinolytic enzymes are produced by many bacteria, earthworms, and snake toxin, but there have been few productions of the fibrinolytic enzyme from fungi [6]. In the present study, an attempt was made for the isolation, production and partial purification of the fibrinolytic enzyme from Aspergillus carbonarius S-CSR-0007 isolated from soil samples near slaughter house.
MATERIALS AND METHODS
The media used in this study were obtained from HiMedia Laboratories, India and chemicals used were of analytical grade.
Instruments used for the study
Orbital shaking incubator (Remi Elektrotechnik Limited, India), UV-Vis spectrophotometer (Thermo Scientific Evolution 201), electronic balance (Shimadzu AY220).
Isolation and cultivation of fungal isolates
Soil samples were collected from various locations near slaughter house. Samples were collected by scraping off the soil surface, and 10 g of soil were obtained from a depth of 2-5 cm. Fungi present in the soil was isolated by serial dilution and spread plated on Sabouraud Dextrose agar (SDA) medium with 50 ppm of tetracycline and incubated at room temperature for five days.
After five days, observed for the colonies in the incubated plates. The fungal colonies were subcultured to freshly prepared SDA and PIA with tetracycline (50 ppm) plates for the purification of colonies grown. The subcultured plates were incubated at room temperature for 28-72 h.
For the further confirmation of microorganisms, the fungal cultures were stocked on SDA and PIA slants. The fungal spores were inoculated to fresh plates by using 0.1% tween 80 solutions in sterile distilled water. The fungal plates were spread with 0.1% tween 80 solution and spores were dislodged by using a sterile glass rod. The spore suspension was inoculated to SDA and PIA plates with tetracycline (50 ppm).
Preparation of blood clots for nitrogen source
Buffalo blood was collected from slaughterhouse. The blood was allowed to clot for overnight at room temperature. Then the clots were shredded by using a surgical blade and placed in 1 L of distilled water in a beaker. The beaker was placed on the magnetic stirrer for further shredding and RBC removal. Water was replaced every half an hour. Repeated this procedure until the clot became grey in color. This clot was ground into fine powder by using mortar and pestle and dehydrated by using acetone. This powder was used as a source of fibrin and stored at 4 °C.
Screening of fibrinolytic organism
The isolated organisms were spot inoculated on minimal medium containing powdered fibrin. The plates were incubated at room temperature for three days. Fibrinolytic organisms were showed a clear hallow around the colony, and the organism produced large zone was selected for further studies. The fungi with fibrinolytic activity were stock cultured on SDA slant with tetracycline (50 ppm) at 4 °C.
Identification of organism
The fungal species grown in the media were identified macroscopically and microscopically by using staining methods like saline wet mounting and LPCB (Lacto Phenol Cotton Blue) staining.
Determination of caseinolytic activity
This method was used to detect the proteolytic activity of the organism. Casein agar was prepared by using 1% casein. The organisms were spot inoculated on the medium and incubated at room temperature for 3 d. Observed the colonies, proteolytic organisms showed clear hallow around the colony, indicating casein hydrolysed by the organism.
Production of fibrinolytic enzyme
Modified Czapekdox medium was used, consisting of the following ingredients (g/l) 5 casein, 5 sucrose, 30 KH2PO4, 1.0 MgSO4.7H2O, 0.5 KCl and 0.5 FeSO4.7H2O; all ingredients were dissolved in 1,000 ml distilled water. Two different substrates casein and fibrin (0.25%) were added to the Czapekdox medium. 50 ml of the media were transferred to 250 ml conical flask and sterilized by autoclaving at 121 °C for 20 min and cooled to room temperature. One ml of uniformly prepared spore suspension (105spores ml-1) from 7 d old cultures was used as inoculums (Aspergillus carbonarius). Inoculated medium was incubated at 37 °C in orbital shaker for 48 h at 100 rpm.
Extraction of fibrinolytic enzyme
After 5 d, the content of the flasks was filtered through Whatman No.1 filter paper. Culture filtrates were centrifuged at 5,000 rpm for 10 min and the supernatant was used as the crude enzyme.
Enzyme assay
The reaction mixture containing 2.0 ml of 0.5% casein solution in 0.1 ml of carbonate buffer (pH 9.3) and 0.1 ml of enzyme solution in the total volume of 2.1 ml [10]. Then the reaction mixture was assayed [7]. Absorbance was taken at 660 nm in UV spectrophotometer.
Optimization of cultural conditions
For the fibrinolytic enzyme production, three factors were selected; they are substrate concentration, pH and temperature. The effect of three factors on fibrinolytic enzyme production was experimented [8].
Effect of substrate concentration on enzyme production
To study the effect of substrate concentration on enzyme production, 1 ml of uniformly prepared spore suspension (105spores ml-1) from 7 d old cultures was used as inoculum and incubated at different substrate concentrations such as 1% to 4%. Inoculated medium was incubated at 37 °C in orbital shaker for 48 h at 100 rpm and then estimated its enzyme activity.
Effect of pH on enzyme production
The production medium was adjusted at different pH levels such as pH 4.0 to 9.0 using 0.2 molar with specific buffer solutions. One ml of uniformly prepared spore suspension (105spores ml-1) from 7 d old cultures was used as inoculums. Inoculated medium was incubated at 37 °C in orbital shaker for 48 h at 100 rpm and then estimated its enzyme activity.
Effect of temperature on enzyme production
To study the effect of incubation temperature for maximum fibrinolytic enzyme production, solution was incubated at different temperatures such as 20 °C to 60 °C. One ml of uniformly prepared spore suspension (105spores ml-1) from 7 d old cultures was used as inoculums. Inoculated medium was incubated at 37 °C in orbital shaker for 48 h at 100 rpm and then estimated its enzyme activity.
Protein estimation
Quantitative estimation of the protein content of individual fraction obtained after different steps was done [7].
Partial purification by ammonium sulphate precipitation method
The crude enzyme (100 ml) was placed in a salt-ice bath. Ammonium sulphate was added for saturation, at varying concentration of 20%, 40%, 60%, 80% and 100% with a constant stirring ice bath for 1h. Precipitated protein was removed by centrifugation at 1,000 rpm for 20 min at 4 °C. Then the supernatant was discarded [9]. The precipitated protein was dissolved in 50 mmol Tris-HCl (10 ml), pH 7.0, assayed for determining enzyme activity and protein content [7].
Dialysis of the partially purified enzyme
Dialysis bag (8 cm) was cut and placed in 100 ml of 2% (w/v) sodium bicarbonate and 1 mmol EDTA was added to chelate any metal ions. It was boiled for 10 min and washed with boiling distilled water for 10 min. The boiling process was repeated with distilled water again. The activated dialysis bag was filled with the enzymes and sealed from the both sides without any air bubbles using dialysis bag closure clips. The bag was kept in 500 ml of 50 mmol Tris-HCl, pH 7.0 solution on a magnetic stirrer in ice cold condition for 8 h. The buffer was frequently changed at an interval of one hour to avoid equilibration [10].
Characterization of the partially purified enzyme
Effect of temperature
The enzyme was assayed in the reaction mixture containing 2.0 ml of 0.5% casein solution in 0.1 M carbonate buffer (pH 4.0) and 0.1 ml of enzyme solution in the total volume of 2.1 ml. After incubation at 20 °C, 25 °C, 30 °C, 35 °C, 40 °C, 45 °C, 50 °C, 55 °C, 60 °C and 65 °C for 5 min, the reaction was stopped by adding 3.0 ml of 10% ice cold TCA solution [10]. The reaction mixture was filtered by using Whatman No 1 filter paper and the enzyme activity was assayed [7].
Effect of substrate concentration
The enzyme was assayed in the reaction mixture containing 2.0 ml of different concentration of 0.25%, 0.5%, 1%, 2%, 3% and 4% casein solution in 0.1 M carbonate buffer (pH 4.0) and 0.1 ml of enzyme solution in the total volume of 2.1 ml. After incubation at 37 °C for 5 min the reaction was stopped by adding 3 ml (10%) of ice cold TCA [10]. The reaction mixture was filtered by using Whatman No 1 filter paper and enzyme activity was measured [7].
Effect of pH
Buffer with different pH of 4.5 to 9.5 was prepared [11]. Reaction buffer (2 ml) with different pH was taken in a test tube, and 0.1 ml of enzyme sample was added. The samples were incubated at 37 °C for 5 min. After incubation, the reaction was stopped by adding 3 ml (10%) of ice cold TCA [10]. The reaction mixture was filtered, and enzyme activity was measured [7].
Determination of enzyme stability
Enzyme stability was determined to find out at what conditions the enzyme can be stored by maintaining its maximum activity and stability [11].
Enzyme stability at different temperature
Supernatant (0.5 ml) was added into different test tubes. Each tube was incubated at different temperatures (20, 25, 30, 35, 40, 45, 50, 55, 60 and 65 °C). 0.5 ml of carbonate buffer with 0.5% casein of pH 4.0 was added into each test tube and incubated at 37 °C for 10 min. After incubation, the reaction was stopped by adding 3 ml (10%) of ice-cold TCA. The reaction mixture was filtered and enzyme activity was measured [7].
Enzyme stability at different pH
Supernatant (0.5 ml) was mixed with 0.5 ml of 0.1 molar buffers at different pH ranges in different test tubes (pH: 2.5, 3.0, 3.5, 4.0, 4.5, 5.0, 5.5, 6.0, 6.5, 7.0, 7.5, 8.0, 8.5, 9.0, 9.5, 10.0 and 10.5) and incubated at 37 °C for 10 min. After incubation, the reaction was stopped by adding 3 ml (10%) of ice-cold TCA. The reaction mixture was filtered, and enzyme activity was measured [7].
In vitro activity of fibrinolytic enzymes
For the determination of fibrinolytic activity of produced enzyme, 5 ml of buffalo blood was collected from the slaughterhouse. The collected blood was filled into the capillary tube and kept at room temperature for 45 min. Blood clots were formed inside the capillary tube, and the tube was cut at length of 5 mm. Pieces of capillary tube were placed in petridish and enzyme extract was added to it; kept at room temperature for 15 min. After 15 min, the lysis of clot inside the capillary tube by the fibrinolytic activity of enzyme extract was observed.
RESULTS
Isolation and identification of fungal isolates
Fibrinolytic fungi from soil samples were collected from various locations near slaughter house. The fungal isolates grown on SDA and PIA plates with 50 ppm of tetracycline were identified macroscopically and microscopically by using staining methods like saline wet mounting and LPCB (Lacto Phenol Cotton Blue) staining. Seven fungal isolates were identified as Aspergillus niger, Aspergillus fumigatus, Aspergillus carbonarius, Aspergillus flavus, Mucor sp., Penicillium sp. and Rhizopus sp.
Screening of fibrinolytic fungi
Fibrin plate agar showed clear zone around the spotted fungi (fig. 1) indicates the fibrinolytic activity, were used for further studies. Samples could be collected from dump yards of beef, fish and milk centers and fibrinolytic activity of organism was determined by using fibrin plate agar [12].
Fig. 1: Fungal isolates were grown on fibrin-agar
Identification of fibrinolytic fungi
Aspergillus carbonarius (fig. 2) from soil samples were collected from various locations near slaughter house. The fungal isolates grown on SDA and PIA plates with 50 ppm of tetracycline were identified macroscopically and microscopically by using staining methods like saline wet mounting and LPCB (Lacto Phenol Cotton Blue) staining.
Fig. 2: Growth of Aspergillus carbonarius S-CSR-0007 on SDA
A new strain of the Aspergillus carbonarius S-CSR-0007 was isolated from the soil sample showed fibrinolytic activity towards fibrin as substrate.
Determination of caseinolytic activity
The isolated sample was tested to break down casein. On casein agar the isolated organism Aspergillus carbonarius S-CSR-0007 showed clear zone around the colony that means the organism hydrolyzes casein (fig. 3).
Fig. 3: Aspergillus carbonarius S-CSR-0007 on Casein agar
Production and extraction of fibrinolytic enzyme
Aspergillus carbonarius S-CSR-0007 was used for the enzyme production.
Submerged fermentation using different growth substrate
Two different growth substrates, casein, and fibrin (0.25%) were used for the production of the enzyme, in which the growth substrate casein was given maximum enzyme production (table 1).
So casein was used as a growth substrate for further studies.
Table 1: Effect of growth substrate on enzyme production
| S. No. | Substrate | Enzyme activity (U/ml) |
| 1 | Casein | 816 |
| 2 | Fibrin | 459 |
The ability of the crude enzyme of Aspergillus carbonarius S-CSR-0007 to digest different growth substrates was studied using fibrin and casein (0.25%). BSA was used as the standard. Results indicated that at 10 min incubation the crude enzyme was able to digest the protein substrates were tested. Casein was rapidly digested to give 816 U/ml tyrosine compared to fibrin which gave 459 U/ml of tyrosine.
Enzyme assay
The activity of enzyme achieved was about 510 U/ml when compared to tyrosine.
Protein estimation
Protein content was estimated using BSA as standard [7] and the amount of protein present is 10 mg/ml.
Optimization of cultural conditions
Effect of three factors on fibrinolytic enzyme production by Aspergillus carbonarius S-CSR-0007 experimented, and the results are shown in (fig. 4, 5 and 6). Optimum pH, temperature and substrate concentration for maximum enzyme production was found to be 5.0, 40 °C and 3.5% respectively.

Fig. 4: Effect of pH on enzyme production n=6

Fig. 5: Effect of substrate concentration on enzyme production n=8

Fig. 6: Effect of temperature on enzyme production n=5
The result showed that the production of the enzyme is at pH 4.0 to 6.0 with an optimum enzyme activity of 1750 U/ml at pH 5.0, there was a decrease in pH values at higher values. The optimum temperature and substrate concentration for the enzyme production was at 40 °C with an enzyme activity of 330 U/ml, and 3.5 with an enzyme activity of 2200 U/ml respectively.
Partial purification of fibrinolytic enzyme
Ammonium sulphate precipitation method followed by dialysis
The culture supernatant of Aspergillus carbonarius S-CSR-0007containing an initial enzyme activity of 510 U/ml was concentrated by varying concentrations of ammonium sulphate precipitation followed by dialysis. Varying concentrations of ammonium sulphate precipitation screening was carried out to determine the best percentage of ammonium sulphate saturation which gave the highest fibrinolytic activity [13]. The result for ammonium sulphate saturation on the precipitation of fibrinolytic enzyme from Aspergillus carbonarius S-CSR-0007 was shown in fig. 7. The optimum ammonium sulphate saturation was at 80% with an enzyme activity of 1,200 U/ml.

Fig. 7: Enzyme activity at different concentrations of ammonium sulphate n=5
Characterization of the partially purified enzyme
Effect of temperature on enzyme activity
The activity of the partially purified enzyme was determined at various temperatures ranging from 20 °C to 55 °C. From the results (fig. 8), it showed that at 45 °C enzyme production was maximum with the enzyme activity of 2091 U/ml.

Fig. 8: Effect of temperature on enzyme activity n=8
Effect of substrate concentration on enzyme activity
Different concentrations of substrates were applied to investigate their effect on enzyme production. The result (fig. 9) shows that the enzyme activity increases with increase in substrate concentration. The maximum fibrinolytic activity showed at 4% substrate concentration was 1224 U/ml.

Fig. 9: Effect of substrate concentration on enzyme activity n=6
Effect of pH on enzyme activity
The influence of pH on the activity of the partially purified enzyme was determined using buffers at various pH values. The result (fig. 10) indicates that enzyme shows its highest enzyme activity 1130 U/ml at pH 7.0. The enzyme activity increases with increase in pH till 7.0, above that the enzyme activity decreases gradually.

Fig. 10: Effect of pH on enzyme activity n=10
Enzyme stability
Enzyme stability was determined to find out at what conditions the enzyme can be stored by maintaining its maximum activity. At this condition, the enzyme remains most stable.
Effect of temperature on enzyme stability
Enzyme stability was determined to find out at what conditions the enzyme can be stored by maintaining its maximum activity. At these conditions, the enzyme remains most stable. The thermal stability of the enzyme was measured for 10 min at pH 4.0. The enzyme was stable in the temperature range of 40-50 °C and rapid decrease in activity was observed at a temperature above 50 °C (fig. 11).

Fig. 11: Effect of temperature on enzyme stability n=9
Effect of pH on enzyme stability
The effect of pH on the enzyme stability of the enzyme was determined using buffers at various pH values. A fibrinolytic enzyme produced by Aspergillus carbonarius S-CSR-0007 was stable over a broad pH range of 6.0-9.0 with a maximum stability at pH 8.0 (fig. 12) at temperature 37 °C for 20 min.

Fig. 12: Effect of pH on enzyme stability n=12
In vitro activity of fibrinolytic enzymes
Blood clot inside the capillary tube was lysed by the fibrinolytic activity of the partially purified enzyme (fig. 13) within 15 min and no lysis was observed in control (fig. 14).
![]() |
![]() |
| Fig. 13: Fibrinolysis by the enzyme | Fig. 14: Control-showing no fibrinolysis |
DISCUSSION
A fibrinolytic enzyme such as urokinase and streptokinase are very costly and can be used through intravenous administration. The result shows that the best nitrogen source for the fibrinolytic enzyme production by Aspergillus carbonarius S-CSR-0007 was casein. Several investigators studied the effect of different nitrogen sources on enzyme production. Marine Pseudomonas strain 1452, produces extracellular protease by using casein as nitrogen and carbon source [14]. Most of the higher fungi prefer organic and ammoniacal nitrogen sources than inorganic nitrogen sources [15]. The fibrinolytic enzyme from Ganoderma lucidum showed maximum fibrinolytic enzyme production with peptone as the nitrogen source [16]. In the future, we can concentrate on purification of the enzyme from fungus.
Optimum enzyme activity of enzyme production in this study was seen at pH 5.0, Schizophyllum commune BL23 and in Serratia marcescens [9] showed maximum enzyme production at pH 6.0. Cordyceps militaris showed maximum enzyme production at pH 7.0 [17]. The optimum temperature for the enzyme production in this study was at 40 °C which was relatively high compared to previous reports in Cordyceps militaris, Schizophyllum commune BL23, and Serratia marcescens which were 25 °C, 32 °C and 35 °C respectively.
Ammonium sulphate salt is mostly used in precipitation process due to its low cost and high solubility, compared to other solvents and there is no effect on pH and temperature by this salt [18]. Based on the result, the crude enzyme shows very low enzyme activity at 20-60% ammonium sulphate saturation, indicated that the protein did not tend to aggregate and salt out of culture solution due to low ammonium sulphate concentration. However, the fibrinolytic activity increases at 80% of ammonium sulphate concentration. This indicated that the fibrinolytic enzyme precipitated at 80% ammonium sulphate concentration gave the highest enzyme activity of 1200 U/ml. When compared to the crude enzyme, the enzyme activity increased more than two times with 80% ammonium sulphate saturation.
Aspergillus carbonarius S-CSR-0007 showed maximum enzyme activity at 45 °C. With the increase in temperature enzyme activity increases until 45 °C and enzyme activity declined suddenly after 45 °C. This is due to the velocity of enzymatic reaction increases with the increase in temperature within limited range because of increase of kinetic energy of molecule until it reach to the degree of maximum reaction velocity, but the increase of temperature at ranged which lead to disruption of the three-dimensional structure of the enzyme and then decreases its velocity [19]. This result agrees with the fact that the influence of temperature on fibrinolytic activity from Rhizopus chinensis 12 with an optimum activity was 45 °C [20], from Streptomyces sp. CS684 [21] and with Streptomyces sp., showed optimum enzyme activity 45 °C [22]. The optimum temperature for fibrinolytic enzyme was 40 °C [2].
Aspergillus carbonarius S-CSR-0007 showed maximum enzyme activity at pH 7.0. This result agrees with a study on Bacillus lichniformis B4 with an optimum pH for maximum enzyme activity at 7.0 [8]. The fibrinolytic enzyme from Cordyceps militaris shows maximum enzyme activity at pH 7.0-8.0 [17] and Rhyzopus chinensis 12 showed optimum pH 7.6 [20].
The enzyme was stable at 40-50 °C and rapid decrease in temperature observed above 50 °C, fibrinolytic enzyme from Tricholoma saponaceum and Armilleriella mellea was stable at 55 °C. Enzyme from Rhyzopus chinensis 12 showed stability at 6.8-8.8 [20]. However, an enzyme from Aspergillus carbonarius S-CSR-0007 shows higher stability when compared to others previous reports [20, 23, 24, 25]. The fibrinolytic activity in Flammulina valutipes was inactivated completely at 55 °C within 15 min [26]. Some previous studies showed that the fibrinolytic enzyme was relatively stable at a temperature lower than 40 °C and lost all initial activity after 10 min at 60 °C [27]. The fibrinolytic enzyme from the other organisms was stable in pH range of 7.0-9.0 [24 26, 28]. Enzyme from Streptomyces sp. showed max enzyme stability only at 37 °C and at 45 °C to 55 °C the enzyme lost its 60% activity. So this enzyme is superior among fibrinolytic enzyme.
It showed lysis of the blood clot by the enzyme within 15 min, and from this, it is proved as a promising fibrinolytic agent, and fibrinolytic activity can be further improved by purification.
CONCLUSION
The goal of this study is to produce, purify and characterize fibrinolytic enzyme from fungal species. This study concludes that Aspergillus carbonarius S-CSR-0007 has the capacity to produce highly thermostable high pH stable fibrinolytic enzyme which could have broad applications in many industries. However, further work on purification and the molecular basis of the thermostable and high pH stable capacity of the enzyme from Aspergillus carbonarius S-CSR-0007. In future, it can be an alternative cultivation system for microbial products which are costly because fungi have been utilized in solid state fermentation [29]. This enzyme showed high blood clot lysis activity, which may be a good candidate in the pharmaceutical industry.
Intravascular thrombosis is one of the main causes of CVD in human. In the present study, Aspergillus carbonarius S-CSR-0007 has been studied for the optimal production of fibrinolytic protease. Optimization of various parameters for enzyme production was carried out. Optimum pH for the enzyme production was seen at pH 5.0. The optimum temperature for the enzyme production was at 40 °C. Aspergillus carbonarius S-CSR-0007 showed maximum enzyme activity at pH 7.0 and at a temperature of 45 °C. The enzyme was stable at 40-50 °C and rapid decrease in temperature observed above 50 °C, The partial purification of the enzyme was carried out by ammonium sulphate precipitation method and dialysis. An in vitro clot lysis assay was performed using the partially purified enzyme. The enzyme showed fibrinolytic activity within 15 min.
CONFLICTS OF INTERESTS
The authors declare no conflict of interest.
REFERENCES
How to cite this article